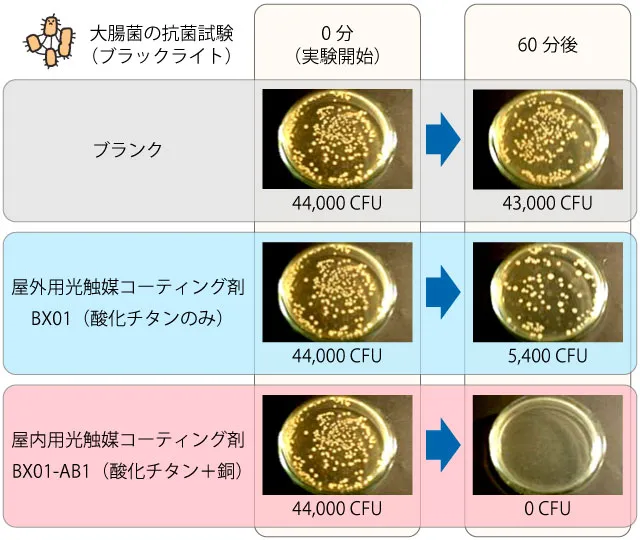
酸化チタンと銅ドープ酸化チタンによる大腸菌の抗菌試験結果（ブラックライト）

屋内用光触媒コーティング剤(BX01-AB1)による大腸菌抗菌試験を、佐賀大学農学部にて行っていただいた結果をご紹介したいと思います。
屋内用光触媒コーティング剤(BX01-AB1)とは、銅ドープ酸化チタンを使った光触媒コーティング剤です。
銅ドープ酸化チタンは、酸化チタンに酸化銅を結合させたナノ粒子のことです。
酸化チタンは、紫外線が当たったときでないと抗菌力を発揮しませんが、銅ドープ酸化チタンは蛍光灯の光といった、室内の照明器具の明かりでも抗菌力を発揮します。
また、ナノサイズの酸化銅が、無光でも触媒効果を発揮して、抗菌をしてくれます。
それの実証試験として、大腸菌の抗菌試験を行っていただいた次第です。
比較として、ブランクと酸化チタンと比べています。
ご紹介する結果は、あくまでも試験環境での結果ですから、いかなる環境でも大腸菌の抗菌を保証するものではございませんので、あらかじめご理解のほどをお願いします。
紫外線(ブラックライト)を当てたとき
まず、紫外線(ブラックライト)を当てたときの結果です。試験環境では、酸化チタンは若干大腸菌が残っていますが、銅ドープ酸化チタンですと60分後に大腸菌が死滅していることがわかります。
銅ドープ酸化チタンは、酸化チタンに結合されたナノサイズの酸化銅が、補触媒の効果を発揮し、酸化チタンの効果を高めているようです。
蛍光灯の光を当てたとき

蛍光灯を当てたときは、酸化チタンは反応が著しく弱くなっています。それに対して銅ドープ酸化チタンも、紫外線と比べると若干効果が落ちているようですが、高い抗菌力を発揮しています。
無光のとき

紫外線と蛍光灯の光では60分後の結果でしたが、無光のときは、効果がさらに弱くなるので、180分後の試験結果になります。
酸化チタンは、ブランクとほぼ同程度ですから、無光では酸化チタンは抗菌ができていません。
それに対して銅ドープ酸化チタンは、無光でも抗菌ができています。
無光でも抗菌ができる性質を持つ光触媒は、抗菌剤として実用化されている光触媒の中では、銅ドープ酸化チタンのみです。
銅ドープ酸化チタンを使った抗菌コーティング施工や抗菌加工は、イリスまでお気軽にご相談ください。


